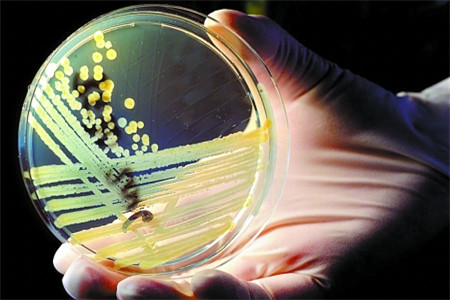
德国肺炎病毒

德国新冠肺炎确诊超17万,解封后多地暴发集体感染
继美国意大利英国俄罗斯等国之后,德国新冠肺炎累计确诊超过17万。多个地区解封后爆发了集体感染,面对疫情的紧急扩散,不少地区暂停了解封,继续坚持封城防疫政策,以此来抑制疫情的传播。

德国疫情最新消息
截止到05月9号13时,德国新冠肺炎确诊病例达到了170588例,其中治愈141700例,死亡7510例,现有病例21378例。
德国疫情快速突破17万,多数是因不少地区实行了6日宣布的解封境警戒线,距离解封短短两三天的时间,有不少的县市确诊人数都超过了红线。据悉德国方面宣布,若是解封之后连续七天新增确诊超过50例,那将会再次进行封城。然而解封短短几天,东部图林根州的格赖茨、西部北威州的科斯费尔德和北部石荷州的施泰因堡,新增病例就突破了红线,北威州的科斯费尔德当天就宣布暂停解封,继续严格遵循防疫政策。

科斯费尔德出现集体感染的地方是在一家肉联厂,据悉过去七天内该县每10万居民新增确诊达到了52.7人,远超红线,因此该县决定将解封政策延后一周。
格赖茨和施泰因堡在解封之后也出现了集体感染的情况,施泰因堡是在养老院中出现了不少的感染病例,而格赖茨则是屠宰场出现了集体感染。
德国新冠肺炎累计确诊超17万,死亡7千多。面对严峻的疫情,及早的开启解封导致了多地爆发了集体感染,小编想说在现有病例还有2万的情况下,在新冠肺炎病毒依旧肆虐的情况,不要抱着侥幸的心理,继续在家隔离才是最好的防疫手段,建议德国地区继续做好防控工作,研究好跟病毒共存的阶段政策,只有这样才能避免传播,还能重启经济哦。

















